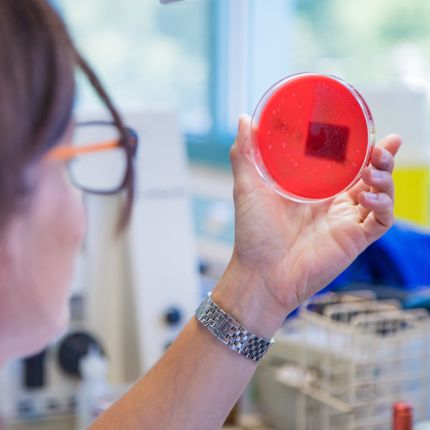

Servizi clinici e diagnostici

L'Ente Ospedaliero Cantonale collabora con i medici invianti anche attraverso una serie di specialità cliniche che offrono una diagnosi accurata e terapie avanzate.

L'Ente Ospedaliero Cantonale collabora con i medici invianti anche attraverso una serie di specialità cliniche che offrono una diagnosi accurata e terapie avanzate.

Dedica solo pochi istanti per condividere ciò che pensi del nuovo sito www.eoc.ch. Le tue opinioni sono importanti per migliorare l'esperienza di tutti.
Compila il sondaggio ora!